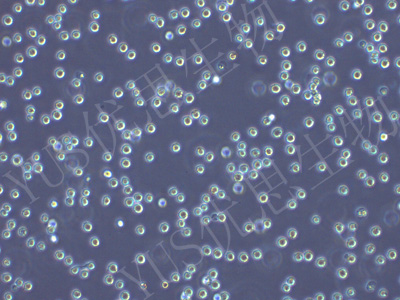

产品中心
人源细胞系
Hep G2 人肝母细胞瘤细胞(STR鉴定)
货号:YLH370
规格:
1*10^6
价格: ¥1500
产品信息
| 名称 | Hep G2 人肝母细胞瘤细胞(STR鉴定) |
| 别名 | HEP-G2; Hep G2; HEP G2; HepG2; HEPG2 |
| 种属 | 人 |
| 细胞形态 | 上皮细胞样 |
| 生长特性 | 贴壁生长 |
| 培养条件 | MEM(含NEAA)+10% FBS+1% P/S。气相:空气,95%;二氧化碳,5%。温度:37℃。湿度:70%-80% |
| 推荐传代比例 | 1:2-1:3 |
| 换液频率 | 2-3次/周 |
| 冻存条件 | 冻存液:90% FBS+10% DMSO;温度:液氮 |
| 背景描述 | 该细胞系来自15岁男性白人的组织。形态为上皮细胞样,模式染色体数为55,在免疫抑制小鼠中不致瘤。 |
| 组织来源 | 肝母细胞瘤 |
| 生物安全等级 | BSL-1 |
注意事项
1.收到细胞后,若发现干冰已挥发干净、冻存管瓶盖脱落、破损及细胞有污染,请立即与我们联系。
2.收到细胞先不开瓶盖,瓶身擦拭酒精后放在培养箱静置2-4小时(视细胞密度而定)稳定细胞状态。接着在倒置显微镜下观察细胞生长情况,并对细胞进行不同倍数拍照(建议收细胞时就整体外观拍一张照片,观察培养基的颜色和是否有漏液情况,随后在显微镜下拍下细胞状态,100*,200*各一张),观察记录细胞在运输过程中是否有污染情况。作为我方进行销售依据。
3.由于细胞状态受环境、操作和运输等多方面因素影响,故本公司只保证客户收到细胞后一周内的细胞状态,故客户需要售后时需出示收到细胞的时间证明及客户提供收货时间和发现问题后客服人员沟通的时间证明,期间间隔时间不能大于7天。
4.所有动物细胞均视为有潜在的生物危害性,必须在二级生物安全台内操作,并请注意防护,所有废液及接触过此细胞的器皿需要灭菌后方能丢弃。
5.在细胞培养过程中,有任何技术问题您可以拨打技术售后服务电话:027-59901947,我们随时给予解答。
推荐产品
在线咨询
Online consultation

关注微信公众号